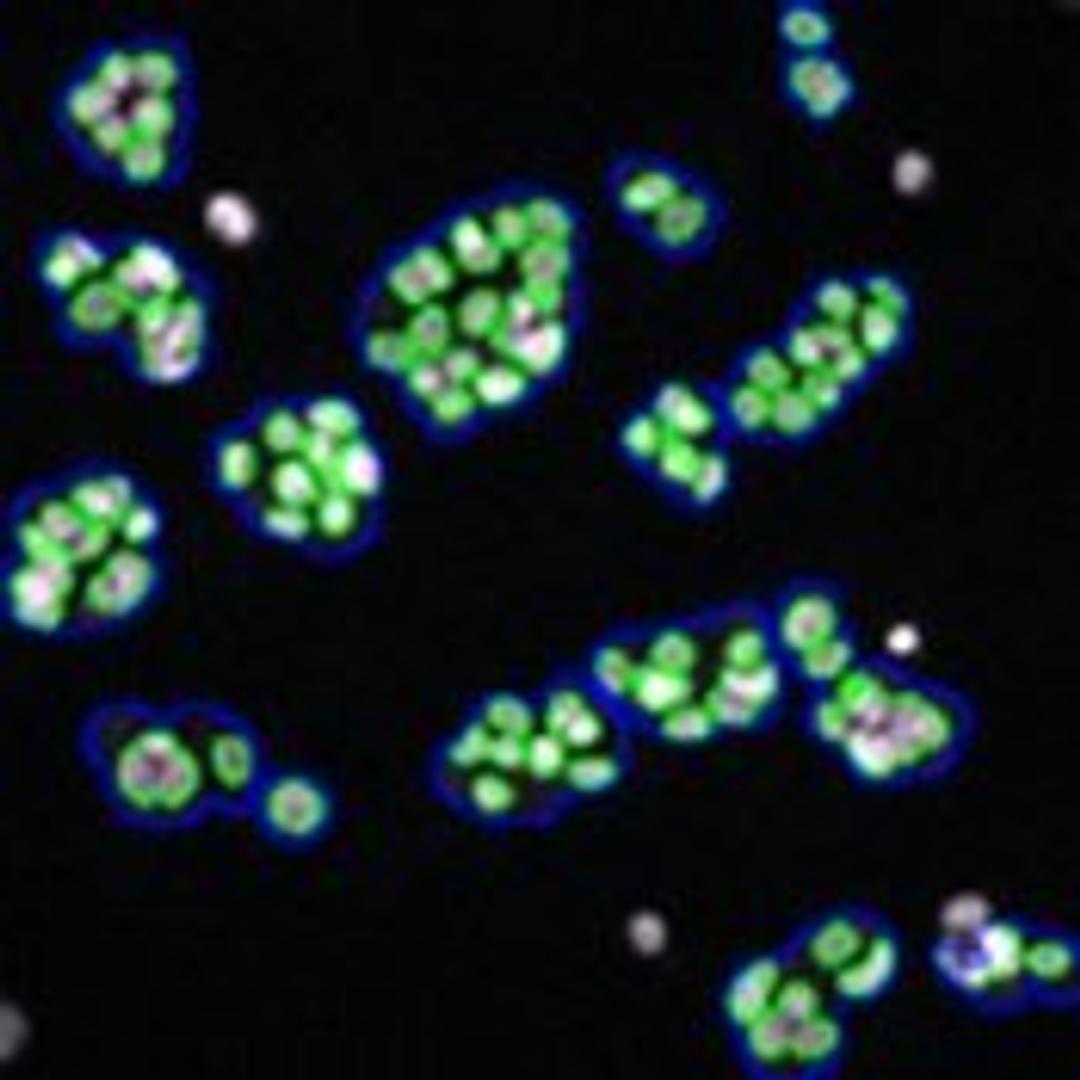

Morphology Explorer V2 Image Analysis BioApplication
Morphology Explorer V2 is a powerful general-purpose image analysis application for measuring size, shape, and distribution of cells, colonies, and subcellular components. It performs sophisticated calculations in a turn-key, automated manner allowing higher throughput of complex cell-based assays. This application has been biologically validated, enhancing confidence in your image-based data. Available for the Cellomics…
Morphology Explorer V2 is a powerful general-purpose image analysis application for measuring size, shape, and distribution of cells, colonies, and subcellular components. It performs sophisticated calculations in a turn-key, automated manner allowing higher throughput of complex cell-based assays.
This application has been biologically validated, enhancing confidence in your image-based data. Available for the Cellomics ArrayScan VTI, ArrayScan x.5, and KineticScan platforms.